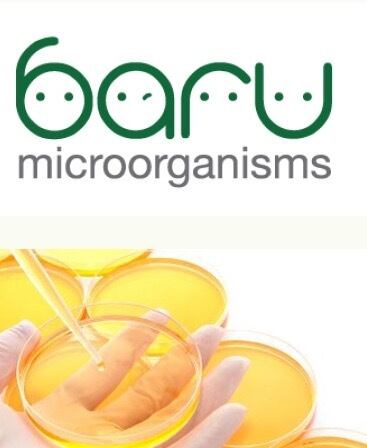

農業用活性液 業務用 農業 野菜栽培 果樹栽培 安心 安全 散布 土壌改良 悩み解決 植物活力剤 散歩 農業用 微生物剤
¥19,800
International shipping available
【商品】 baru乳酸菌エキス
20リットル (約2反以上使用可能)
野菜・花・果樹・水稲の栽培に!
【家庭用はこちら】
https://barubiojapan.base.shop/items/45976720
新発見の微生物を基に、乳酸菌、酵母、枯草菌などをミックスし、GSLBIOの特許技術で作り上げた天然成分100%の微生物資材です。
植物の生育ステージに合せ希釈濃度を調整し、灌水または葉面散布でお使いいただけます。
詳細は自社ホームページはまたはインスタグラムをご覧ください。
http://baru-bio-japan-yoshimura.com/product.html
https://www.instagram.com/baru.bio/
【生育促進】
・肥料効果アップ
微生物のチカラで肥料を低分子化するので、植物の肥料吸収率が向上。
生育に必要な栄養素を、植物が受け取りやすくします。
また、微生物が活動することで、有機酸・アミノ酸が生産されます。
有機酸はミネラル成分を植物が利用しやすい形に変え、アミノ酸は旨味や甘味に好影響を与えます。
追肥のタイミングで、baru複合乳酸菌を散布していただくのも効果的です。
・土壌改良
微生物が活動する際に発生する粘質物で、土が糊付けされ団子状に寄り合うことで団粒化が進み、植物の生育に適した、通気性・排水性・保水性・保肥性に優れた団粒土となっていきます。
baru複合乳酸菌は土壌環境をより良くし、植物の理想的な生長を促進します。
【強い農作物へ】
baru複合乳酸菌が植物の根の周りに集まりガードします。
特に乳酸菌の生産する有機酸は、農作物をつよくする効果があると言われています。
地上部分もbaru複合乳酸菌の葉面散布でガードしましょう。
【一般的な使用方法】
・土壌改良(播種1ヶ月前頃) 希釈倍率:原液~50倍
・生育初期(播種~若葉) 希釈倍率:100倍/7~10日間隔
・生育中期~収穫前 希釈倍率:50倍~150倍/7~10日間隔
・予防! 希釈倍率:20~30倍/3~6日間隔
【内容量】 20リットル
※灌水・葉面散布どちらでもお使いいただけます。
※上記はあくまでも目安です。作物や土壌の状態に合わせてご使用ください。
※本資材は生菌剤です。殺菌剤、除草剤との併用は著しく効果が減少します。
※お届けから6ヶ月以内のご使用をお勧めしています。
※冷暗所で保管いただくと、保存期間が長くなります。
※便利なコック付き
【BARU複合乳酸菌の特徴】
BARU複合乳酸菌は、酵母、枯草菌などを中心に有用な微生物を含んだ安心安全な乳酸菌です。BARU複合乳酸菌を使用することにより・農作物の土壌環境改善・強い農作物が育つ低コストで高収穫、高収益を実現します。一般家庭で使用する場合は以下の用途でも使用できます。
・プランターでのちょっとした家庭菜園に。
・生ゴミに使用すると堆肥化し、臭いが消える!
・キッチンの油汚れを分解!
-
レビュー
(0)